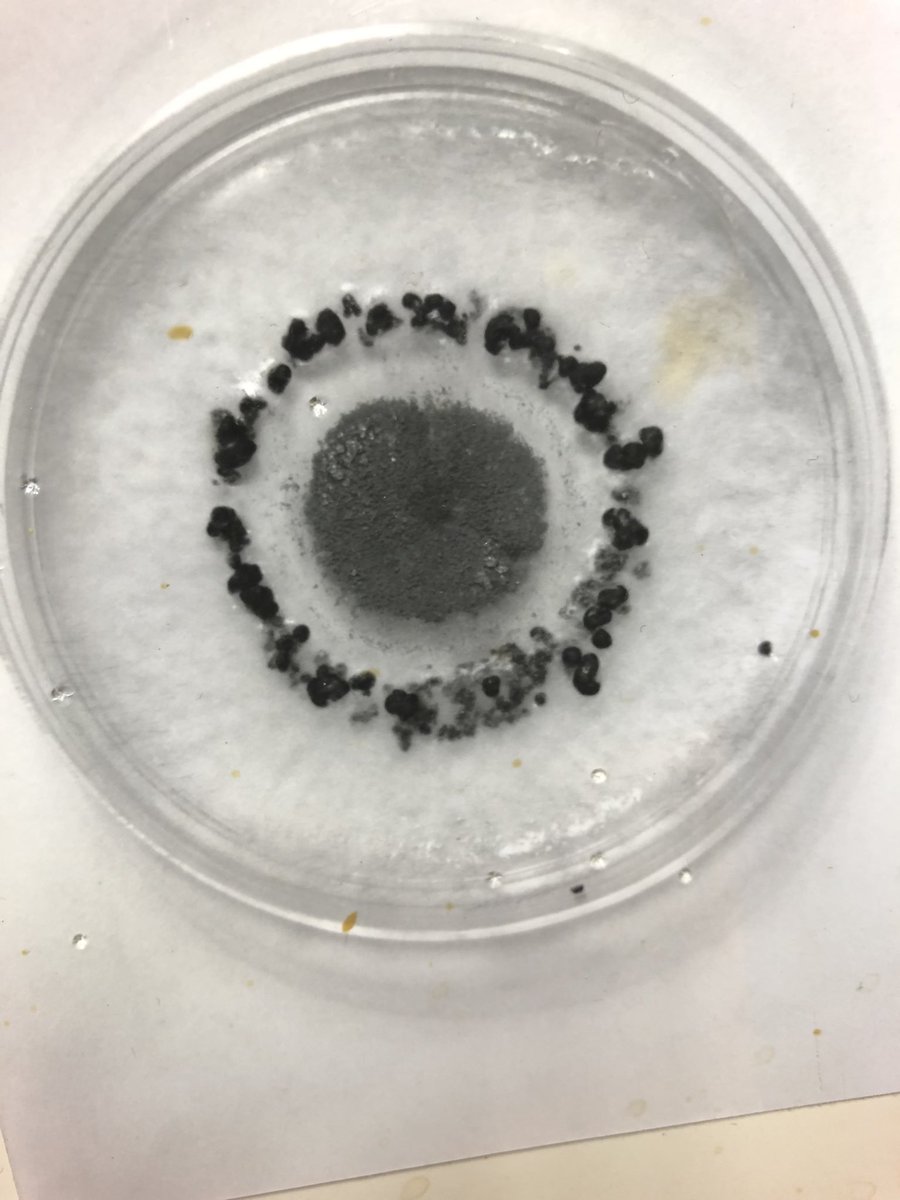
Is this a defense mechanism or a survival mechanism?
Take a look at how a Botrytis cinerea reacted to a Cladosporium sp colony.
The Botrytis surrounded the Cladosporium by making a barrier wall with his sclerotia, thus securing nutrients for itself or keeping his territory safe!

Mohamed T. Nouri
@mohamed_t_nouri
California agricultural Plant Pathologist: Technical Advisor at UPL-DECCO US Post-Harvest.
ID: 1284191133501808640
17-07-2020 18:20:20
56 Tweet
244 Followers
431 Following



The Quad County Walnut Institute will be held in Stockton on February 28. Come to hear great talks on walnut quality, husk fly, mold, soil water infiltration, phytophthora, and more! Mohamed T. Nouri Jhalendra Rijal sjvtandv.com/upcoming-event…

CE Pomology Advisor Roger Duncan and I will be starting our Tree & Vine IPM Breakfast meeting series beginning tomorrow, March 1. Every other Wednesday from March 1 through June (8 meetings). UCCE Stanislaus County UC Statewide IPM Program SacValleyOrchards San Joaquin Valley Trees and Vines - UC ANR Here is more info:



The IX International Olive Symposium abstract submission deadline was extended to March 30th! Make sure to follow IX International Olive Symposium 2023 for more updates! #ISHS_Olive2023 #Olive #Horticulture #UCD #UniversityofCalifornia #CAGrower








The atmospheric rivers of this past #winter have created the right conditions for plant pathogens that haven't been seen for decades in #California. "Generally, whenever you have rain events, you're going to have problems, Florent Trouillas. Mae Culumber bit.ly/42X2Euf


Don't let the cool and late #2023season fool you on #grape #mildew #botrytis management. #Mildew pressure has been absent and mild until Memorial Day. Next week 60 F to 85 F won't help it and cloudy and humid days make it worse. Ag&Natural Resources UC Statewide IPM Program Matthew Fidelibus



Happy to share our latest publication on Phytopathologia Mediterranea Phytopathologia Mediterranea "Identification and pathogenicity of Alternaria species causing leaf blotch and fruit spot of apple in California" 🍎🔬🍄 oajournals.fupress.net/index.php/pm/a…


Our latest publication on Plant Disease is out! 🎉 "Identification and Pathogenicity of Fungal Pathogens Associated with Branch Canker and Shoot Blight on Persimmons (Diospyros kaki) in California" 🔬doi.org/10.1094/PDIS-1…